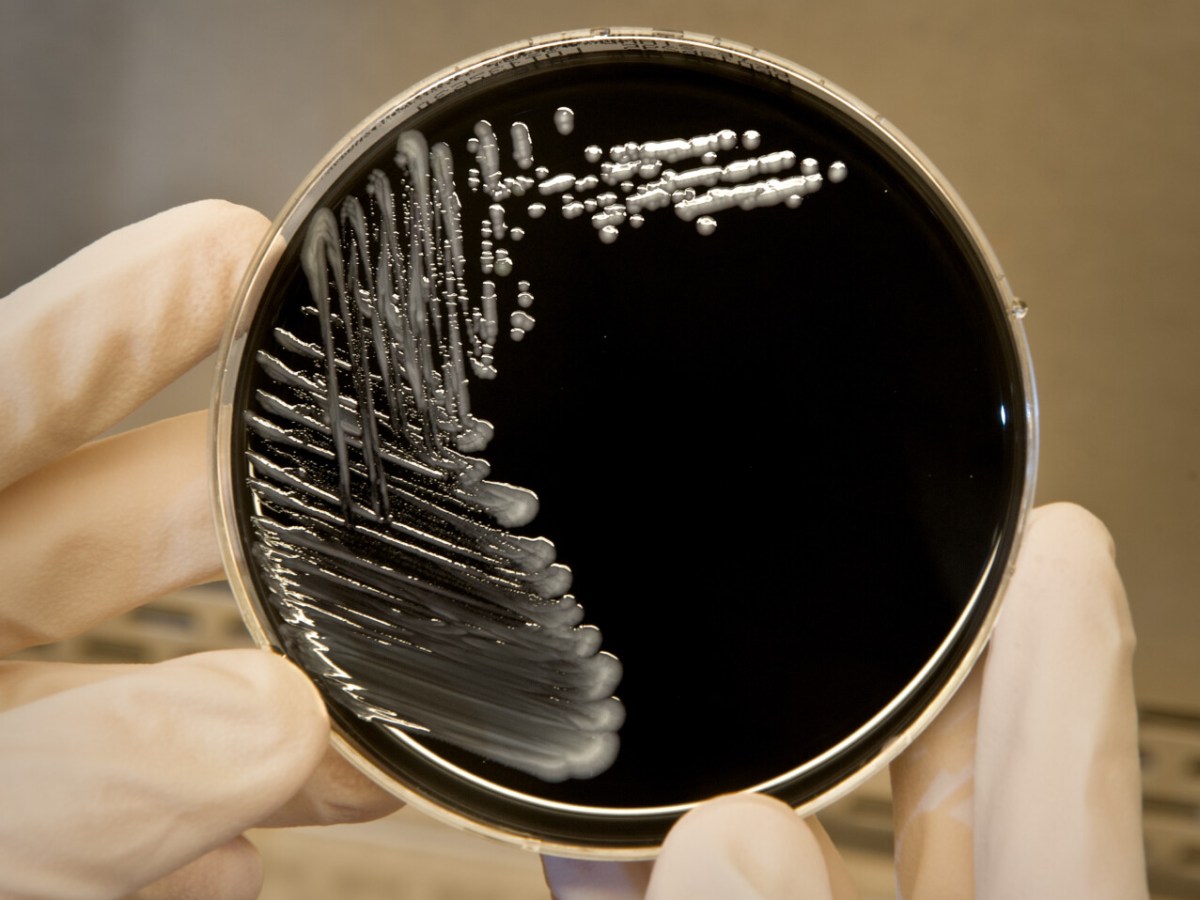

Gov. Janet Mills is considering whether it is ‘appropriate’ to prohibit all e-cigarette products in Maine, a spokeswoman says.
maine center for disease control
Maine health authorities find EEE virus in mosquitoes in York County
The potentially deadly virus is found in a single mosquito pool in Lebanon.
State warns of hepatitis A exposure from Boothbay Harbor cruise business
An infected food service worker could have exposed recent patrons of Cap’n Fish’s Boothbay Harbor Boat Trips to the contagious liver disease.
State health officials issue warning about mosquito-borne disease
Maine has not seen any human cases of Eastern Equine Encephalitis since 2015, but there have been 4 cases and 1 death in Massachusetts recently.
Maine health officials looking for links in 6 cases of Legionnaire’s disease
The CDC is trying to determine whether there are any connections between the cases in the Bangor area, including one in which the patient died.
Pertussis rate continues to rise in Maine, with 39 new cases last month
The number of cases is running well ahead of last year, when Maine had the nation’s highest rate for the infectious disease also known as whooping cough.
Maine rolls out new ‘hub’ for browntail moth information
Mainers can now call or text 211 to speak to a specialist about the invasive species that causes heath problems.
Vaccinated child had Maine’s first case of measles in 2 years, say health officials
The case was confirmed Monday in a school-aged child in Somerset County, and the agency says others may have been exposed at schools in Madison and the hospital in Skowhegan.
Mumps case reported at York High School
The Maine Center for Disease Control said other students may have been exposed at the high school and at a basketball game at Massabesic High School.
Mills administration aims to bring Maine CDC back to full strength
DHHS Commissioner Jeanne Lambrew says the LePage administration let 111 jobs in the Center for Disease Control and Prevention – about 25 percent of its workforce – remain vacant.